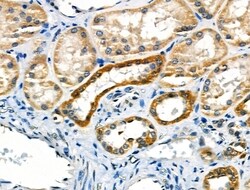
Invitrogen COX17 Polyclonal Antibody 100 &mu;L; Unconjugated:Antibodies,

missing translation for 'onlineSavingsMsg'
Learn More
Learn More
Invitrogen™ COX17 Polyclonal Antibody


Rabbit Polyclonal Antibody
Brand: Invitrogen™ PA5104527
This item is not returnable.
View return policy
Description
Antibody detects endogenous levels of total COX17.
Cytochrome c oxidase 17 (COX17) is a nuclear gene encoding an assembly protein necessary for proper COX apoenzyme-dependent mitochondrial respiration. The mammalian COX apoenzyme is a heteromer consisting of three mitochondrial genes that encode catalytic subunits and several nuclear genes that encode structural subunits. COX17 influences the recruitment of copper to the mitochondria for incorporation into the COX apoenzyme.
Specifications
| COX17 | |
| Polyclonal | |
| Unconjugated | |
| COX17 | |
| AI037035; Cox17; COX17 cytochrome c oxidase assembly homolog; COX17 cytochrome c oxidase copper chaperone; COX17 homolog, cytochrome c oxidase assembly protein; COX17, cytochrome c oxidase copper chaperone; Cox17a; cytochrome c oxidase 17 copper chaperone; cytochrome c oxidase assembly homolog 17; cytochrome c oxidase assembly protein 17; cytochrome c oxidase copper chaperone; cytochrome c oxidase subunit XVII assembly protein homolog; cytochrome c oxidase, subunit XVII assembly protein homolog; human homolog of yeast mitochondrial copper recruitment | |
| Rabbit | |
| Affinity Chromatography | |
| RUO | |
| 10063, 12856, 89786 | |
| -20°C | |
| Liquid |
| Immunohistochemistry (Paraffin), Western Blot, Immunocytochemistry | |
| 1 mg/mL | |
| PBS with 50% glycerol and 0.02% sodium azide; pH 7.4 | |
| P56394, Q14061 | |
| COX17 | |
| A synthesized peptide derived from human COX17(Accession Q14061), corresponding to amino acid residues M1-I38. | |
| 100 μL | |
| Primary | |
| Human, Mouse, Rat | |
| Antibody | |
| IgG |
Product Content Correction
Your input is important to us. Please complete this form to provide feedback related to the content on this product.
Product Title
Spot an opportunity for improvement?Share a Content Correction